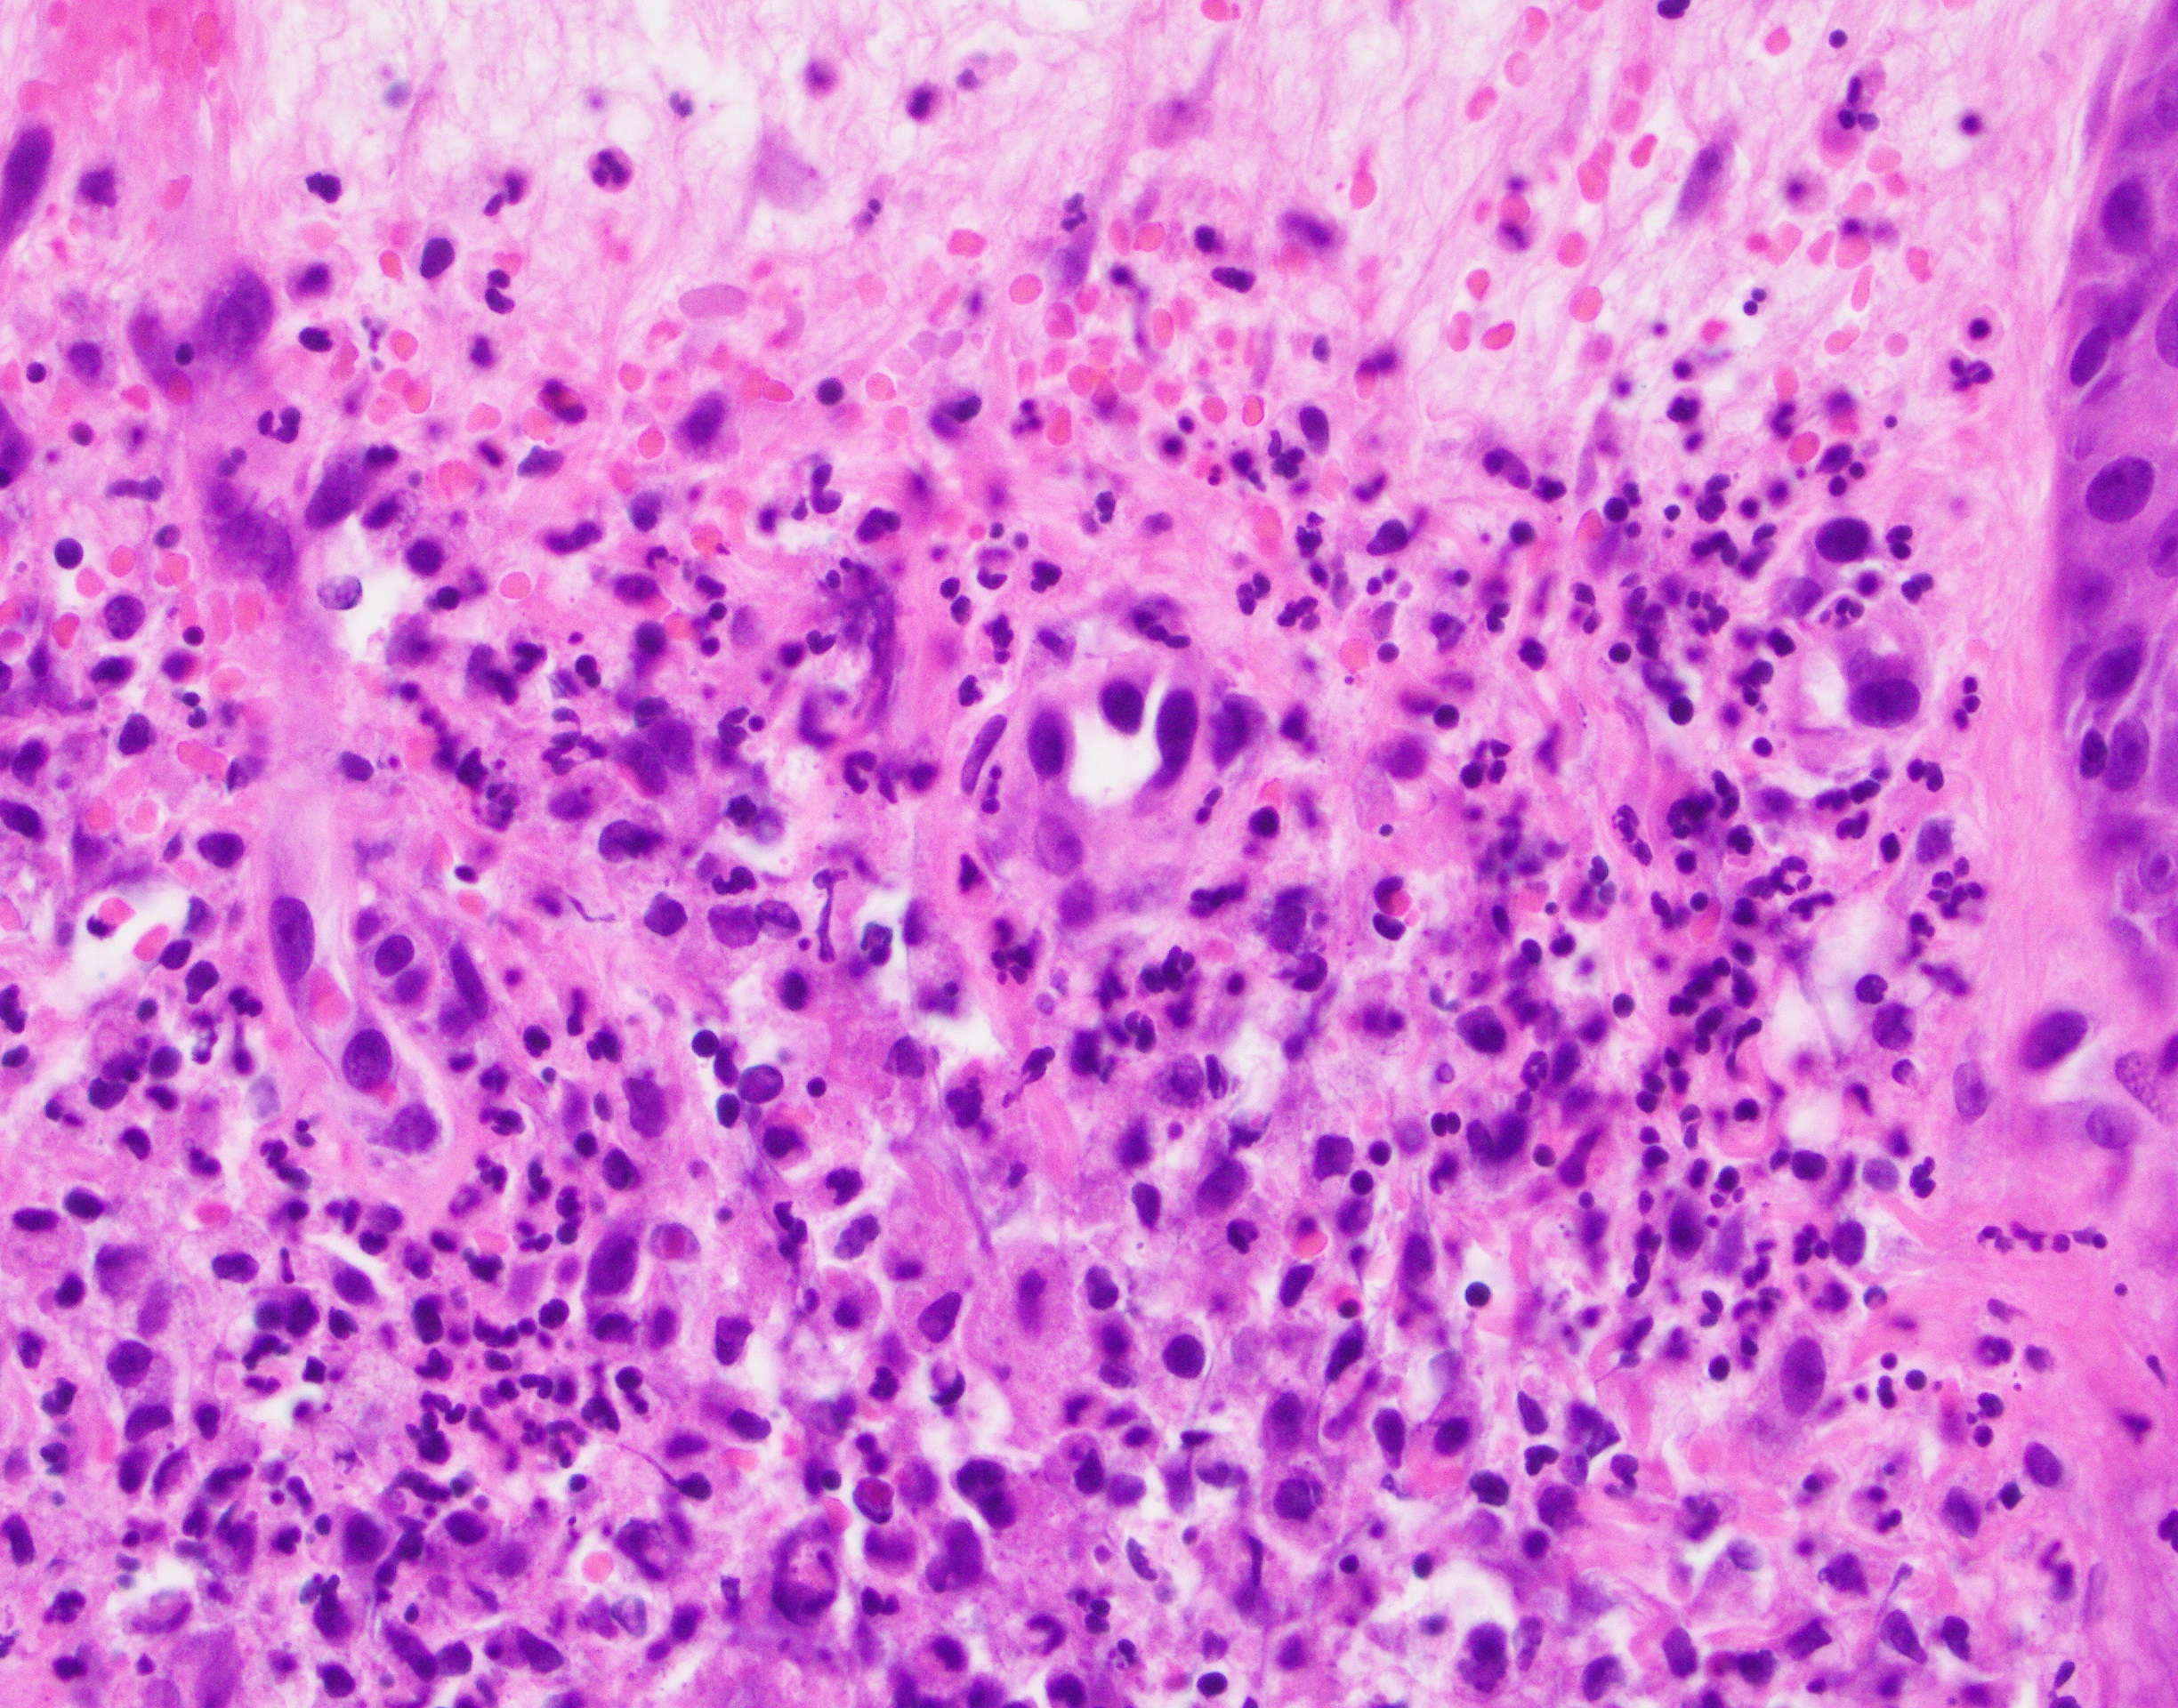

Микропрепараты: Лимфогранулематоз и Нодулярный Склероз

Раздел: Секреты мастерства